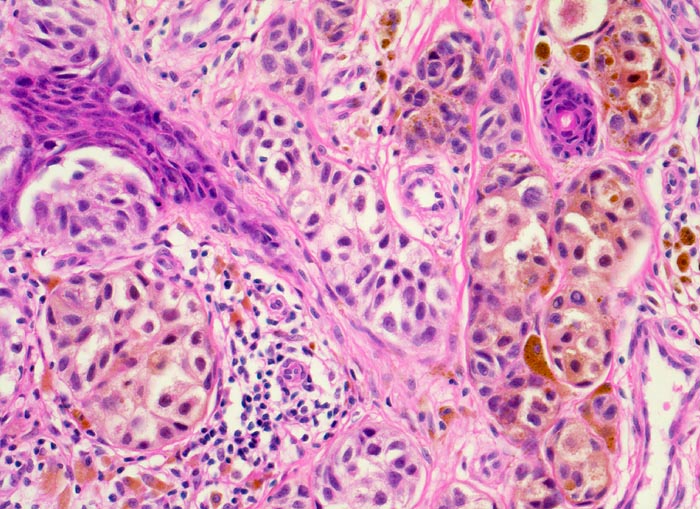

PathoPic – image database / PathoPic ID 3961 - oberflächlich spreitendes Melanom (SSM)
de
Diagnose
oberflächlich spreitendes Melanom (SSM)
Diagnose Gruppe
maligner Tumor
Topographie
Haut, untere Extremität
Topographie Gruppe
Haut
Beschreibung
Ballen von grossen zytoplasmareichen melanozytären Zellen mit ausgeprägter Pigmentierung in der papillären Dermis. Die melanozytären Zellen zeigen keine Ausreifungstendenz zur Tiefe hin.
Zusatzbefund
Leicht erhabener scharf begrenzter brauner in der Mitte
dunkelbraun gefärbter Bezirk, max. Dm 15mm
Infiltration des Stratum papillare bis an das Stratum reticulare
und einer max. Tumordicke von 1,12mm (pT2; Clark Level III).
Klinik
Verdächtiger Nävus Kniekehle links.
Bilder Typ
Histologie
Vergrösserung
200
Alter
43
Geschlecht
unbekannt
Datum
Ersteintrag: 13.01.2002
Update: 04.02.2024